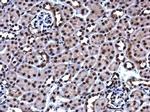
HMGB1 Antibody in Immunohistochemistry (Paraffin) (IHC (P))

Search
Invitrogen
HMGB1 Monoclonal Antibody (GT349)
{{$productOrderCtrl.translations['antibody.pdp.commerceCard.promotion.promotions']}}
{{$productOrderCtrl.translations['antibody.pdp.commerceCard.promotion.viewpromo']}}
{{$productOrderCtrl.translations['antibody.pdp.commerceCard.promotion.promocode']}}: {{promo.promoCode}} {{promo.promoTitle}} {{promo.promoDescription}}. {{$productOrderCtrl.translations['antibody.pdp.commerceCard.promotion.learnmore']}}
图: 1 / 8
HMGB1 Antibody (MA5-31473) in ICC/IF

Please note: We are reviewing Western blot images included in the antibody testing data in our catalog, including those provided by third parties. Unless expressly labeled or annotated as “raw-unedited”, Western blot images included in the antibody testing data in our catalog may have been edited, optimized or otherwise adjusted for presentation.
产品信息
MA5-31473
种属反应
宿主/亚型
分类
类型
克隆号
抗原
偶联物
形式
浓度
规格
纯化类型
保存液
内含物
保存条件
运输条件
RRID
产品详细信息
Keep as concentrated solution.
Predicted reactivity: Mouse (100%), Rat (100%), Xenopus laevis (93%), Dog (100%), Pig (100%), Rabbit (100%), Chicken (94%), Rhesus Monkey (100%), Bovine (100%).
Positive Control: 293T, A431, HeLa, HepG2, Mouse brain, Rat brain.
Store product as a concentrated solution. Centrifuge briefly prior to opening the vial.
靶标信息
High-mobility group box 1 protein, previously known as HMG-1 or amphoterin, is a member of the high mobility group box family of non-histone chromosomal proteins. Human HMGB1 is expressed as a 30 kDa, 215 amino acid (aa) single chain polypeptide containing three domains: two N-terminal globular, 70 aa positively charged DNA-binding domains (HMG boxes A and B), and a negatively charged 30 aa C-terminal region that contains only Asp and Glu. HMGB1 is expressed at high levels in almost all cells. It was originally discovered as a nuclear protein that could bend DNA. Such bending stabilizes nucleosome formation and regulates the expression of select genes upon recruitment by DNA binding proteins. It is now known that HMGB1 can also act extracellularly, both as an inflammatory mediator that promotes monocyte migration and cytokine secretion, and as a mediator of T cell-dendritic cell interaction. Moreover, HMGB1 is reported that the level of HMGB1 is elevated during sterile tissue injury, infection, lethal endotoxemia or sepsis, collagen-induced arthritis, and ischemia-reperfusion induced tissue injury.
仅用于科研。不用于诊断过程。未经明确授权不得转售。
篇参考文献 (0)
生物信息学
蛋白别名: Amphoterin; Amphoterin antibody; DKFZp686A04236; Heparin-binding protein p30; high mobility group 1; High mobility group protein 1; High mobility group protein B1; HMG-1; HMG3 antibody; hmgb 1; hmgb-1; RP11-550P23.1
基因别名: Ac2-008; amphoterin; DEF; HMG-1; HMG1; HMGB1; p30; SBP-1
UniProt ID: (Rat) P63159, (Mouse) P63158
Entrez Gene ID: (Rat) 25459, (Mouse) 15289



